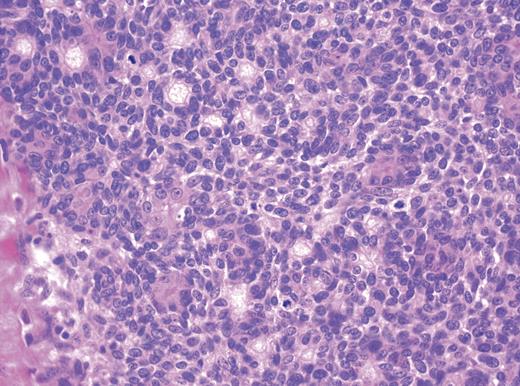
Histology of ADPA showing a high mitotic grade lesion with a small focus of lymphovascular invasion.

-
PDF
- Split View
-
Views
-
Cite
Cite
Samuel G. Coulson, Kim Suvarna, Kathleen S. Dunn, A case report of a rare adnexal tumour: aggressive digital papillary adenocarcinoma, Journal of Surgical Case Reports, Volume 2013, Issue 8, August 2013, rjt065, https://doi.org/10.1093/jscr/rjt065
Close - Share Icon Share
Abstract
We report the case of a 78-year-old Caucasian gentleman who presented with a painful swelling in the nail bed of the right middle finger. Following amputation of the right middle phalanx histopathology confirmed aggressive digital papillary adenocarcinoma (ADPA). Further surgical treatment was offered but declined. Approximately 17 months later, the patient was found to have pulmonary metastasis. ADPA is a rare neoplasm of the eccrine sweat glands, which commonly presents as a slow-growing mass between the nail bed and distal interphalangeal joint. The disease is classically aggressive with a 14% chance of metastatic spread. The chance of recurrence is 50% with no or sub-optimal treatment, which reduces to 5% following removal with adequate resection margins. This case shows a prolonged period of disease-free survival, but highlights the need for thorough and aggressive management in cases of ADPA as well as frequent and long-term follow-up.
INTRODUCTION
Aggressive digital papillary adenocarcinoma (ADPA) is a rare condition, with a small number of case series reported in the literature to guide evidence-based management of the condition. It is a malignancy of the eccrine sweat gland cells and its disease course is characteristically aggressive. The lesion usually occurs between the nail bed and distal interphalangeal joint of the finger, but has also been reported in other locations. The current management is one of surgical excision, requiring in some cases proximal amputation. No evidence exists to support the use of chemotherapy or radiotherapy in its management.
CASE REPORT
A 78-year-old Caucasian gentleman presented with a painful 2 cm irregular swelling in the nail bed of the distal phalanx of the right middle finger, with brown discolouration of the nail bed. The swelling in the digit had been present for ∼30 years, which had begun following a fracture of the terminal phalanx and had gradually increased in size over the preceding 6 months. There was no axillary or cervical lymphadenopathy and the patient was fit and well.
Clinically a differential diagnosis of an aggressive adenocarcinoma was suspected, but this was not supported by multiple radiological investigations. CT and MRI of the lesion showed a vascular destructive lesion that was causing severe erosion of the distal interphalangeal bone (Figs 1 and 2, respectively). A plain chest radiograph at that time showed no pulmonary metastasis.

CT of the right middle finger showing a soft tissue lesion with increased vascularity, cortical irregularity of the distal phalanx and bone erosion.

MRI of the right middle finger showing a vascularly destructive space occupying lesion 23 × 15 × 20 mm in size. The mass was multiloculated and causing severe erosion of distal interphalangeal bone. There lesion was iso-intense on T1 weighting, homogenously hypo-intense on STIR sequences and showed intense homogenous enhancement on post gadolinium fat sat T1 sequences.
As the radiological investigations had shown that the distal phalanx was not viable and a lack of proximal invasion, it was felt appropriate to perform an amputation at the level of middle to distal third of the middle phalanx. Such an amputation was aimed at being curative, in addition to providing a definite diagnosis, maintaining function and allowing for primary closure.
The patient underwent an amputation of the middle phalanx of the right middle finger. Histopathology of the specimen showed a high mitotic grade lesion with a small focus of lymphovascular invasion, diagnostic of ADPA (Fig. 3). The tumour was 0.7 mm from the nearest resection margin. The high rates of recurrence and metastasis were explained to the patient, who declined further surgical treatment.
Histology of ADPA showing a high mitotic grade lesion with a small focus of lymphovascular invasion.
Seventeen months following initial presentation, the patient developed a mass in the right axilla. In addition, subsequent plain chest radiograph (Fig. 4) and CT of the thorax showed multiple pulmonary metastasis. An axillary clearance was performed and one of the ten nodes confirmed metastatic disease. Shortly after this, the patient suffered an intracranial haemorrhage into the right internal capsule. Over the last 2 years the patient has remained only mildly short of breath due to his pulmonary metastasis and was improving neurologically. At a recent review, the patient showed features of deterioration due to the pulmonary metastasis.

Plain chest radiograph taken 17 months after excision of the primary lesion showing multiple pulmonary metastasis.
DISCUSSION
ADPA is a rare neoplasm of the eccrine sweat gland cells. The mean age for patients presenting with this malignancy is 52 years, with cases reported in patients between 19 and 83 years [1]. The primary tumour commonly presents as a slow-growing solitary mass, usually between the nail bed and distal interphalangeal joint [1]. Cases of ADPA have also been reported on the palmar surface of the hand, plantar surface of the foot, the lower leg and the web-spaces of the hands and feet [2]. Rare cases have also been reported on the lips and ears [3]. ADPA is differentiated from adenoma by poor glandular differentiation, necrosis, cytological atypia, mitotic rate and invasion of soft tissue, bone and vasculature [1]. ADPA typically follows an aggressive course in terms of local invasion, with a 14% chance of metastatic spread [1]. With incomplete excision the primary ADPA lesion has a 50% chance of recurrence, which decreases to 5% when the primary tumour is removed completely and with adequate resection margins [4]. Lung tissue is the commonest site for metastasis, with other sites being lymph nodes, brain, skin, bones and kidneys [3]. With the high recurrence rate in mind, the recommended treatment is one of wide local excision of the primary tumour, possibly with proximal amputation, but no objective margin is proffered by the literature [1, 3]. There is also evidence supporting the use of sentinel node biopsy for the staging of ADPA, which could potentially identify a group of patients who may benefit from lymph node dissection thereafter [5, 6]. No evidence to support the use of PET imaging, chemotherapy or radiotherapy is available [1, 6].
This case highlights that a rare malignant tumour, presenting with a swelling of the digit, can mimic benign conditions. Despite significant metastatic disease, this patient has had a prolonged period of symptom-free survival. We have also shown that the axillary node clearance was beneficial as it has controlled axillary disease. ADPA should be treated aggressively, providing clear resection margins. However, it should be understood that even if clearance is achieved, there may be recurrence and/or metastatic spread. Close patient follow-up is recommended for both lymphatic and pulmonary dissemination of the disease.
ACKNOWLEDGEMENTS
The authors would like to acknowledge Mr Michael Edwards who was the Orthopaedic Surgeon involved in this case.
Conflict of interest. No conflicts of interest present.